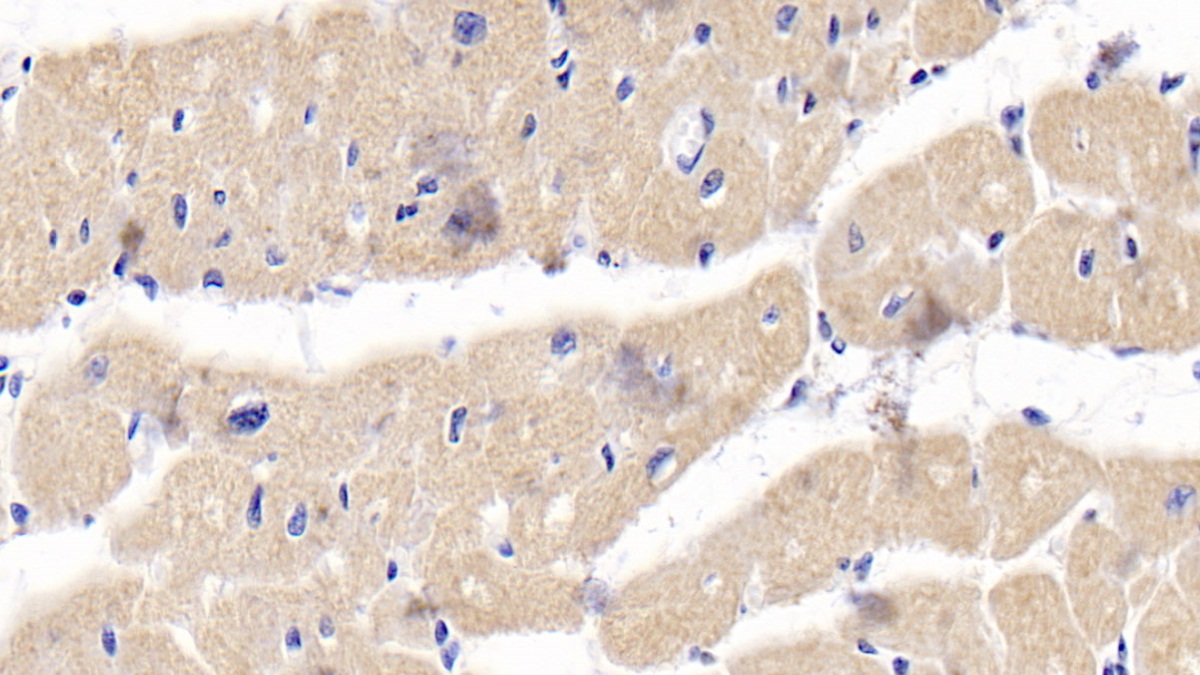
Osteoprotegerin (OPG) Human Polyclonal Antibody

| Pack Size | 100ul, 1ml, 200ul, 20ul |
|---|---|
| Applications | WB; IHC; ICC; IP. |
| Host Species | Rabbit |
| Antibody Type | Polyclonal Antibody |
| Organism Species | Homo sapiens (Human) |
| Concentration | 1 mg/ml |
| Product Synonyms | Osteoprotegerin (OPG) |
| Alternative Names | TNFRSF11B; TNFRSF11-B; OCIF; OPG; TR1; Tumor Necrosis Factor Receptor Superfamily Member 11b; Osteoclastogenesis Inhibitory Factor |
| Immunogen (Antigen) | Osteoprotegerin |
| Buffer Formulation | 50% glycerol., containing 0.02% NaN3, PBS, pH7.4 |
| Reactivity | Po; |
| Uniprot ID | O00300 |
| Gene ID | 4982 |
| Purification | Antigen-specific affinity chromatography followed by Protein A affinity chromatography |
| Usage | For Research Use Only. Not for diagnostics or human use. |
| Shelf Life | 12 months at time of shipping |
| Shipping | Shipped in Dry Ice at -20 Degree Celsius |
| Storage | Store at -20 Degree Celsius. It is recommended to aliquot and store to avoid repeated freeze-thaw as it affects the stability of the antibody. |
| Research Areas | Bone Metabolism |
| Disclaimer | The data indicated herein are as indicated and validated in our laboratory. These reagents are for research use only and not for in-vitro diagnostics or human use. |
Osteoprotegerin (OPG) Human Polyclonal Antibody
$20.00 – $160.00Price range: $20.00 through $160.00
SKU:KDXA112897
Categories:Polyclonal Antibodies
Be the first to review “Osteoprotegerin (OPG) Human Polyclonal Antibody” Cancel reply
Related Products
-
![CAT1 Rabbit Polyclonal Antibody [KD Validated]](https://www.kinesisdx.com/wp-content/uploads/2025/05/A25422_N32165-5_WB_01-370x444.jpg) Sale
Select options This product has multiple variants. The options may be chosen on the product page Quick View Add to wishlistCancer
Sale
Select options This product has multiple variants. The options may be chosen on the product page Quick View Add to wishlistCancerCAT1 Rabbit Polyclonal Antibody [KD Validated]
$100.00 – $430.00Price range: $100.00 through $430.00 -
![CYB5R3 Rabbit Polyclonal Antibody [KD Validated]](https://www.kinesisdx.com/wp-content/uploads/2025/05/A24755_N30496-4_WB_01-370x444.jpg) Sale
Select options This product has multiple variants. The options may be chosen on the product page Quick View Add to wishlistCancer
Sale
Select options This product has multiple variants. The options may be chosen on the product page Quick View Add to wishlistCancerCYB5R3 Rabbit Polyclonal Antibody [KD Validated]
$100.00 – $430.00Price range: $100.00 through $430.00 -
 Sale
Select options This product has multiple variants. The options may be chosen on the product page Quick View Add to wishlist
Sale
Select options This product has multiple variants. The options may be chosen on the product page Quick View Add to wishlist -
![COMT Rabbit Polyclonal Antibody [KD Validated]](https://www.kinesisdx.com/wp-content/uploads/2025/05/A23600_N27285-4_WB_01-370x444.jpg) Sale
Select options This product has multiple variants. The options may be chosen on the product page Quick View Add to wishlistCancer
Sale
Select options This product has multiple variants. The options may be chosen on the product page Quick View Add to wishlistCancerCOMT Rabbit Polyclonal Antibody [KD Validated]
$100.00 – $430.00Price range: $100.00 through $430.00 -
![AARS2 Rabbit Polyclonal Antibody [KD Validated]](https://www.kinesisdx.com/wp-content/uploads/2025/05/A25997_N32217_WB_01-370x444.jpg) Sale
Select options This product has multiple variants. The options may be chosen on the product page Quick View Add to wishlistCell Biology
Sale
Select options This product has multiple variants. The options may be chosen on the product page Quick View Add to wishlistCell BiologyAARS2 Rabbit Polyclonal Antibody [KD Validated]
$100.00 – $430.00Price range: $100.00 through $430.00 -
![Bcl-2 Rabbit Polyclonal Antibody [KD Validated]](https://www.kinesisdx.com/wp-content/uploads/2025/05/A21592_N1199-4C_WB_01-370x444.jpg) Sale
Select options This product has multiple variants. The options may be chosen on the product page Quick View Add to wishlistCancer
Sale
Select options This product has multiple variants. The options may be chosen on the product page Quick View Add to wishlistCancerBcl-2 Rabbit Polyclonal Antibody [KD Validated]
$100.00 – $430.00Price range: $100.00 through $430.00

Reviews
There are no reviews yet.